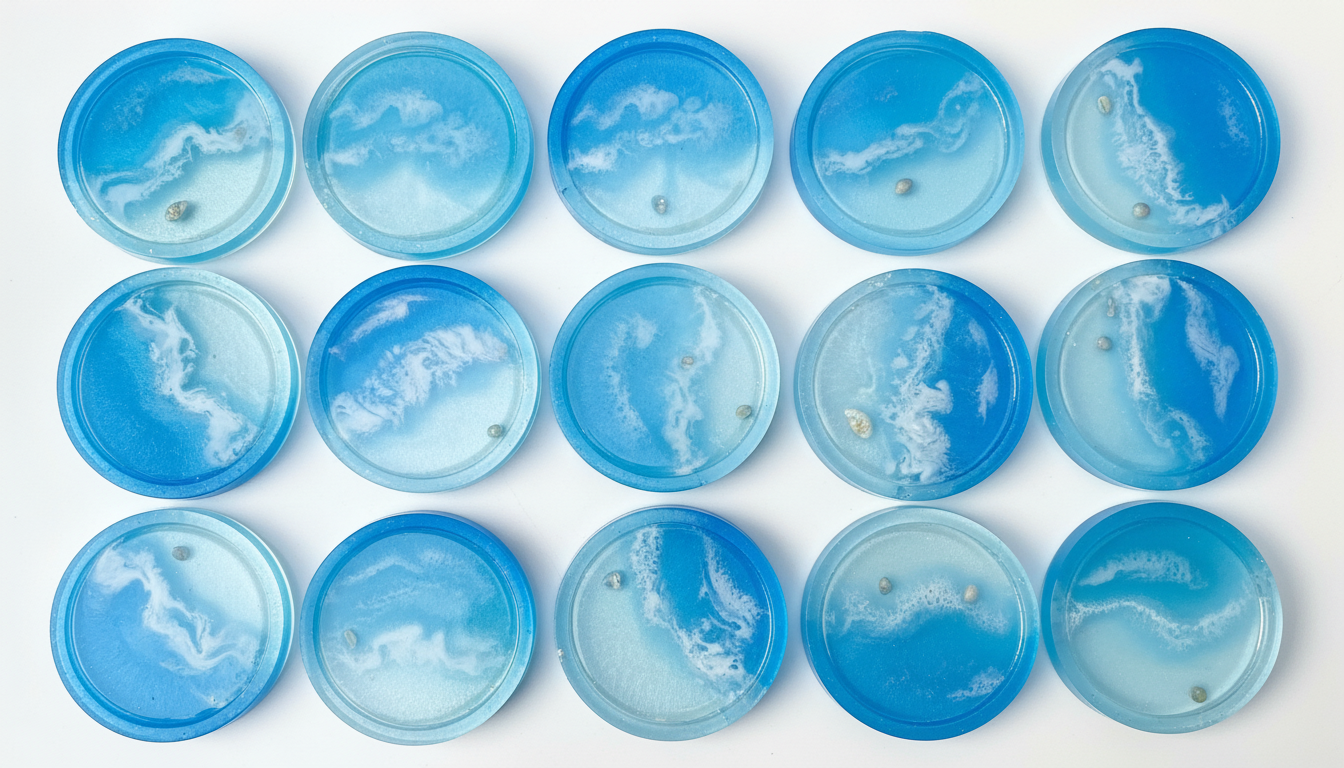
lót ly resin đại dương

Lót Ly Resin Đại Dương: Mang Cả Biển Khơi Vào Ly Nước Của Bạn
Bạn có muốn mỗi lần nhấp môi thưởng thức đồ uống là một lần được du hành đến bờ biển xanh mát? Chiếc lót ly resin đại dương thủ công từ Lành Workshop sẽ biến điều đó thành hiện thực. Với thiết kế độc đáo mô phỏng bãi biển thu nhỏ, đây không chỉ là vật dụng tiện ích mà còn là một tác phẩm nghệ thuật đầy cảm hứng, một món quà tặng ý nghĩa cho người thân yêu. Hãy để mỗi góc nhỏ trong không gian sống của bạn được tô điểm bằng vẻ đẹp trong trẻo và yên bình của biển cả, mang lại cảm giác thư thái sau những giờ làm việc căng thẳng.
Tại Sao Bạn Sẽ ‘Say Sóng’ Với Chiếc Lót Ly Resin Đại Dương Này?
Mỗi chiếc lót ly là một câu chuyện riêng về đại dương, được các nghệ nhân của Lành Workshop chế tác tỉ mỉ bằng cả trái tim. Sự kết hợp giữa màu xanh trong của nước, màu trắng của bọt sóng tạo nên một khung cảnh biển cả thu nhỏ đầy mê hoặc.

Đây không chỉ là một chiếc lót ly, mà là một món đồ decor mang đậm dấu ấn cá nhân. Chúng tôi tin rằng vẻ đẹp không đến từ sự hoàn hảo của máy móc, mà đến từ sự độc nhất của bàn tay con người. Đó là lý do mỗi chiếc lót ly resin đại dương đều mang một linh hồn riêng, không có hai sản phẩm nào giống hệt nhau.
- Thiết kế độc bản, không trùng lặp: Bạn sẽ sở hữu một tác phẩm nghệ thuật duy nhất, vì hiệu ứng sóng và cách phối màu trên mỗi chiếc lót ly được tạo ra hoàn toàn thủ công. Điều này đảm bảo món đồ của bạn là độc nhất vô nhị.
- Chất liệu Resin Epoxy cao cấp, trong suốt như pha lê: Lành Workshop chỉ sử dụng loại nhựa Resin Epoxy chất lượng cao, an toàn cho sức khỏe và có độ trong suốt tuyệt đối, giúp hiệu ứng đại dương trở nên lung linh và có chiều sâu. Chất liệu này cũng có khả năng chống ố vàng, giữ cho sản phẩm bền đẹp theo thời gian.
- Hiệu ứng sóng biển 3D sống động như thật: Bằng kỹ thuật điêu luyện, các nghệ nhân của chúng tôi đã tái hiện thành công hình ảnh những con sóng trắng xóa xô vào bờ cát. Hiệu ứng 3D tạo cảm giác chân thực, như thể bạn có thể nghe thấy tiếng sóng vỗ rì rào.
- Một tác phẩm nghệ thuật thủ công tinh xảo: Từng lớp màu được đổ cẩn thận, từng gợn sóng được tạo hình tỉ mỉ. Đây là thành quả của hàng giờ lao động sáng tạo, mang đến một sản phẩm không chỉ đẹp về mặt thị giác mà còn chứa đựng tâm huyết của người thợ thủ công.
Món Quà Tặng Lót Ly Resin Đại Dương Ý Nghĩa Và Độc Đáo
Bạn đang tìm kiếm một món quà tặng độc đáo và không đụng hàng cho bạn bè, người thân hay đồng nghiệp? Một món quà vừa tinh tế, vừa hữu dụng? Chiếc quà tặng lót ly resin đại dương chính là lựa chọn lý tưởng. Món lót ly resin đại dương này không chỉ là một vật dụng thông thường mà còn là một lời chúc về sự bình yên, thư thái như biển cả. Hãy biến mỗi không gian trở nên thi vị hơn với vật phẩm trang trí nhỏ xinh này, một cách thể hiện sự quan tâm chân thành và gu thẩm mỹ của người tặng.

- Món quà hoàn hảo cho người yêu biển: Đối với những tâm hồn luôn hướng về biển khơi, đây chắc chắn là món quà khiến họ mỉm cười. Mỗi khi sử dụng, họ sẽ được gợi nhớ về những kỷ niệm đẹp với biển xanh, cát trắng, nắng vàng.
- Bảo vệ mặt bàn khỏi nhiệt và vết nước một cách tinh tế: Ngoài vẻ đẹp nghệ thuật, chiếc lót ly resin đại dương còn hoàn thành xuất sắc nhiệm vụ bảo vệ các bề mặt nội thất như bàn gỗ, mặt kính khỏi những vết ố, trầy xước hay ảnh hưởng từ nhiệt độ của ly nước nóng/lạnh.
- Điểm nhấn nghệ thuật cho bàn làm việc, bàn trà: Đặt chiếc lót ly này trên bàn làm việc, bàn khách hay đầu giường, bạn sẽ ngay lập tức tạo ra một điểm nhấn thu hút, mang lại cảm hứng sáng tạo và cảm giác thư giãn. Nó là mảnh ghép hoàn hảo cho những ai yêu thích phong cách trang trí tối giản nhưng vẫn đầy chất thơ.
- Dễ dàng vệ sinh, bền màu với thời gian: Bề mặt resin nhẵn bóng giúp việc vệ sinh trở nên vô cùng đơn giản, chỉ cần một chiếc khăn ẩm lau nhẹ là sạch. Sản phẩm được xử lý chống tia UV, giúp giữ màu sắc luôn tươi mới và không bị phai mờ.
Khám phá thêm => Quà tặng thủ công
Hướng Dẫn Đặt Hàng Và Chăm Sóc Sản Phẩm

Tại Lành Workshop, chúng tôi luôn mong muốn mang đến trải nghiệm mua sắm thuận tiện và dễ dàng nhất cho khách hàng. Để sở hữu chiếc lót ly resin đại dương độc đáo này, bạn không cần phải thực hiện những thao tác phức tạp. Chúng tôi luôn sẵn sàng hỗ trợ bạn qua những kênh liên lạc thân thiện và nhanh chóng nhất.
Cách thức đặt hàng đơn giản và nhanh chóng

Để đặt hàng qua fanpage hoặc số zalo hotline, bạn chỉ cần thực hiện vài bước đơn giản. Nhắn tin trực tiếp cho chúng tôi để nhận được sự tư vấn chi tiết về sản phẩm, các mẫu mã hiện có và chương trình ưu đãi (nếu có). Đội ngũ của Lành sẽ giúp bạn xác nhận đơn hàng và hướng dẫn thanh toán một cách nhanh chóng. Chúng tôi luôn trân trọng từng tin nhắn và cuộc gọi của bạn.
Khám phá thêm => Lành Workshop
Mẹo bảo quản để lót ly luôn như mới
Để tác phẩm nghệ thuật nhỏ bé này luôn giữ được vẻ đẹp ban đầu, bạn vui lòng lưu ý một vài điểm sau:
- Vệ sinh: Dùng khăn mềm, ẩm để lau sạch bề mặt. Không sử dụng các chất tẩy rửa mạnh hay vật liệu cứng, nhám để chà xát.
- Tránh va đập: Mặc dù resin khá bền, việc va đập mạnh hoặc làm rơi có thể gây trầy xước hoặc nứt vỡ.
- Tránh nhiệt độ cao: Không đặt các vật dụng quá nóng (như nồi, chảo vừa nấu xong) trực tiếp lên bề mặt lót ly. Sản phẩm chịu được nhiệt độ của ly nước nóng thông thường.
- Tránh ánh nắng trực tiếp: Để sản phẩm ở nơi thoáng mát, tránh ánh nắng mặt trời gay gắt trong thời gian dài để đảm bảo độ trong và màu sắc được bền lâu nhất.
Khám phá thêm => Lót Ly Resin
Chính sách hỗ trợ và tư vấn tận tình
Sự hài lòng của bạn là ưu tiên hàng đầu của Lành Workshop. Nếu có bất kỳ thắc mắc nào về sản phẩm, cách sử dụng hay cần tư vấn để chọn mẫu lót ly resin đại dương phù hợp nhất, đừng ngần ngại liên hệ với chúng tôi. Đội ngũ Lành luôn sẵn lòng lắng nghe và hỗ trợ bạn một cách tận tình nhất.
Mang Đại Dương Về Nhà Ngay! Liên Hệ Fanpage/Zalo Để Đặt Hàng.
Liên hệ Lành Workshop
🏢 Cơ sở 1: 42 Đường Số 7, KDC CityLand Center Hills, P. Hạnh Thông, Quận Gò Vấp, TP. HCM (thứ 7, chủ nhật)
🏢 Cơ sở 2: Tầng 03, Thiso Mall Trường Chinh – Phan Huy Ích, Quận Gò Vấp, TP. HCM (thứ 7, chủ nhật)
🏢 Cơ sở 3: 1980s Garden – 106 Trần Trọng Cung, Tân Thuận Đông, Quận 7, TP. HCM (thứ 7, chủ nhật)
📞 Hotline/Zalo: 0327.837.877
🌐 Website: www.lanhworkshop.com
LƯU Ý: LÀNH NHẬN SET UP WORKSHOP DOANH NGHIỆP (XUẤT HOÁ ĐƠN VAT) – LIÊN HỆ SỚM ĐỂ NHẬN NGAY ƯU ĐÃI!










